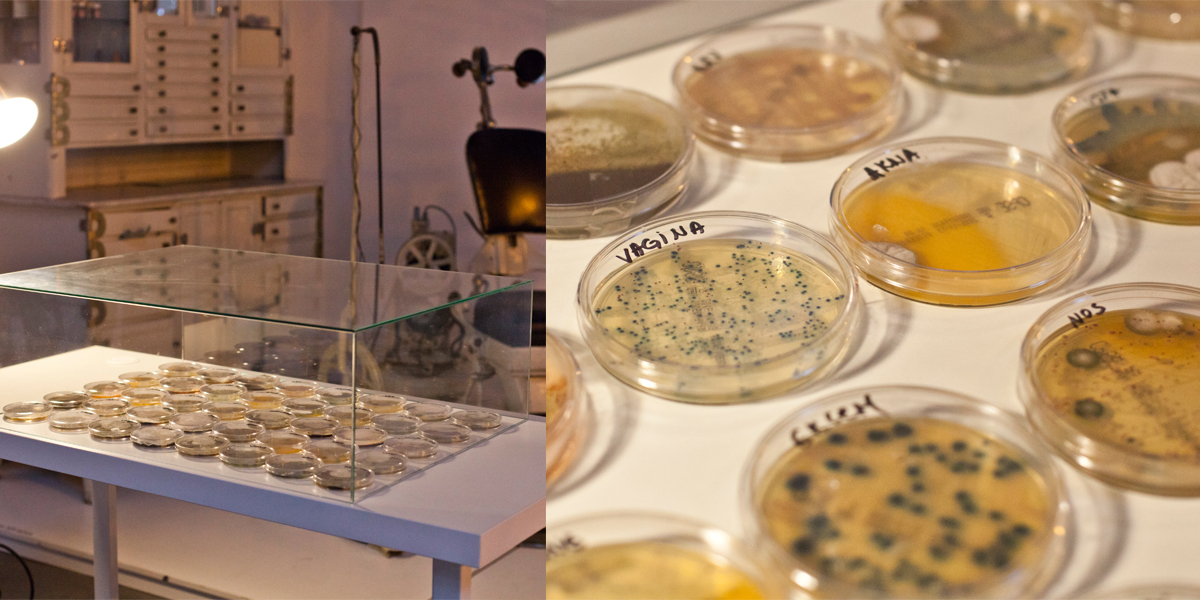
Tijana Radenkovic

Lepota vizuelne umetnosti na Instagramu: Tijana Radenković, vizuelna umetnica, koja između ostalog eksperimentiše i na polju bio-arta, sa nama je na Instagramu podelila lepotu bioloških istraživanja i dozvolila nam da zavirimo u do sada konvencionalno sakrivenu laboratoriju kojoj nismo imali pristup. Tijana je završila Fakultet likovnih umetnosti u Beogradu 2014. godine, trenutno je na doktorskim studijama na istom fakultetu. Bavi se vizuelnim umetnostima i trenutno radi i živi u Beogradu. A za 42 magazin govori o radovima koji u prvi plan stavljaju telo na mikronivou.
Artist’s Portrait, Artist’s Gloves, Artist’s Collection, Artist’s Book, Family Portrait, Physical Identity samo su neki od tvojih radova. Koje bi izdvojila kao značajne?
Do sada sam se bavila uglavnom pitanjem tela, prvenstveno na vizuelnom nivou, telom kao objektom. U jednom trenutku sam se zainteresovala za telo na mikronivou i u tom smislu bih izdvojila svoj projekat Artist’s Portrait, u kome prikupljam bakterije sa svog tela i prebacujem ih u okruženje pogodno za njihov rast i razvoj. Taj rad je do sada bio izložen nekoliko puta (u Muzeju nauke i tehnike, u Muzeju savremene umetnosti u Zagrebu, u Galeriji G12 HUB u Beogradu), ali interesantno je da svaki put kada izlažem taj rad, ja njega radim iznova, jer je privremen i ima svoj vek trajanja. U tom smislu taj rad ima performativni karakter.
Druga interesantna činjenica jeste to da ja nikad ne znam šta mogu da očekujem od tog rada. Svaki put je bilo drugačije, ne samo kako su se bakterije razvile, nego i sam način postavke. Radim sa svojim telom i sa živim organizmima; uzimam brisove sa svog tela i prenosim ih u petri šolje, na podlogu gde se one neko vreme razvijaju i razmnožavaju, nakon čega dolaze u stanje hibernacije i staju da rastu. Sve vreme petri šolje su izložene u galerijama.
Drugi projekat koji bih izdvojila je Artist’s Gloves, gde je reč o potpuno drugom mediju, a u fokusu pitanje masovne proizvodnje i identiteta. Ovaj rad je izveden od gipsanog odlivka sa moje ruke, preko čega je prevučen lateks, i na taj način stvoren je jedinstven, upotrebljiv objekat, u ovom slučaju rukavice od lateksa.
Svaki par rukavica ima etikete, na primer, 100% perfect skin, skin 100% error, 99,9% artist imprint. Tu sam se malo poigravala i idejom o idealnom telu i time šta je naše telo.

Projekat Artist’s Portrait: Tijana prikuplja bakterije sa svog tela i prebacuje ih u okruženje pogodno za njihov rast i razvoj
A šta je naše telo?
Objekat, mehanizam, mašina.
Konkretno, u radu Artist’s Portrait postoji moje fizičko telo i moje telo kao objekat koji nezavisno od mene funkcioniše u nekom drugom prostoru. Dakle, postoje dva tela. Onda se postavlja pitanja gde se nalazim i gde je granica toga ko sam ja. Trenutno radim na jednom novom projektu koji se tiče pitanja granica objekata i mikroorganizama, i taj rad će biti predstavljen u Domu omladine krajem godine.
Dakle, ostaješ u polju mikroorganizama?
Da, meni je to polje jako interesantno. Mi smo neodvojivi od mikroorganizama, živimo zajedno i ne možemo jedni bez drugih, ta veza je neraskidiva. Ali kada se oni iznesu sa našeg tela i stave se na neko drugo mesto, mi postajemo svesniji šta posedujemo i da smo mi u stvari domaćini svim tim mikroorganizmima.
Takođe, volim i biljke i volela bih u budućnosti da radim i na tom polju, ali to zahteva genetsko modifikovanje i to je malo komplikovaniji proces. Danas se u svetu svašta radi, evo na primer umetnik Andrew Pelling od jabuke je bio-modifikacijom napravio uho, zatim umetnički par Revital Cohen i Tuur van Balen u radu Pigeon d’Or uz pomoć kultura bakterija menjaju metabolizam golubova, koji nakon toga u digestivnom traktu proizvode sapun.
Ja sam te pronašla sasvim slučajno na Instagramu i oduševila sam se, mada u prvom trenutku nisam shvatila čime se baviš, kad sam videla sve te silne epruvete, mikroskope, rukavice, pomislila sam da si naučnica….
Da, to tako izgleda jer se služim materijalom koji se koristi u laboratorijama. To je sredstvo kojim se ja služim da kreiram neki umetnički rad. Kao što neko koristi akril ili uljane boje, tako ja koristim brisove sa svog tela i kreiram neki portret, tj. portret mog tela.

Projekat Artist’s Gloves: Svaki par rukavica ima etikete, na primer, 100% perfect skin, skin 100% error, 99,9% artist imprint. Tu se umetnica poigravala i idejom o idealnom telu i time šta je naše telo
Radim sa svojim telom i sa živim organizmima, uzimam briseve sa svog tela i prenosim ih u petri šolje, na podlogu gde se one neko vreme razvijaju i razmnožavaju, nakon čega dolaze u stanje hibernacije i staju da rastu
A onda sam shvatila da je u pitanju bio-art. Da li se izjašnjavaš kao bio-artist?
Ne mogu da kažem da se bavim konkretno bio-artom zato što nemam puno radova koji spadaju u taj domen. Za sada je sve ovo eksperiment. Postoje umetnici koji se mnogo kompleksnije bave time i isključivo rade sa živim tkivima, bakterijama, živim organizmima, koristeći se biotehnologijom, genetskim inženjeringom, kulturama ćelija i tkiva. Neke moje ideje ne idu u tom smeru i ne koristim svaki put žive elemente. Drugi radovi pripadaju potpuno drugačijim sferama, kao što je Current State /Artist’s Collection – foto-dokumenti, zatim fotografije trulog povrća i voća uramljene u barokne ramove, koje su bile izložene u galeriji U10 u sklopu izložbe iScream. Recimo da projekat Artist’s Portrait pripada tom polju jer sam se koristila tim medijem.
Da li je nauka nova umetnost?
Ne znam da li bi se naučnici složili sa tim. To je zapravo spoj te dve stvari jer se umetnik služi nekim materijalom koji iz nekog drugog polja (u ovom slučaju nauke) prebacuje u svoje polje delovanja i rezultat je umetničko delo. E sad mnogi postavljaju pitanje u kom trenutku to postaje umetnost? Takve stvari postoje još od Duchampovog Pisoara, način interpretacije kako objekat dobija umetničku vrednost. Smatram da kao umetnica imam pravo da se služim različitim materijalima, i onog momenta kada rad uđe u neki galerijski prostor ili muzej, postaje umetničko delo. U budućnosti bih volela da se bavim naučnim pristupom u umetnosti, mene to jako zanima, ali zasad možemo reći da je to sve jedan eksperiment.
Da li eksperiment prikupljanja nevidljivih organizama koji nastanjuju naše telo pomera granice ljudske radoznalosti?
Pa naravno da pomera. Ono što je meni najzabavnije kod tog rada jeste činjenica da nikad ne znam šta mogu da dobijem iz toga. Kada uzmete bris i nanesete ga na podlogu, ne mora ništa da pokaže, a sledeći put može svašta da pokaže. Do sada sam to radila tri puta i svaki put je bilo drugačije, svaki put se iznenadite šta imate na svom telu.

A gde misliš da je granica tvoje radoznalosti?
E to ne znam, još uvek ne znam. Uvek sam se bavila umetnošću i imala želju da pravim nešto neočekivano.
A koje su reakcije publike? Kad izložiš rad, da li imaš neka očekivanja kako će reagovati? Da li to bude kako očekuješ ili nikad ne bude tako?
Mnogima je gadno kada vide petri šolje sa bakterijama jer one pod određenom temperaturom puštaju intenzivne mirise. Gadno im je da ih dodirnu. Pitaju me: „Jaoj, kako to možeš da radiš?“, a sa druge strane ima i reakcija gde je ljudima sve to super i oduševljeni su. Sve te reakcije su meni podjednako dobre i važne. Za mene nema loše reakcije.
Evo ja sam ti, na primer, ispod jednog posta ostavila komentar da je tvoj profil jedan od najboljih profila na Instagramu. Kako se osećaš kad dobiješ takve komplimente?
Naravno da mi je drago, svakome bi bilo drago. Ja volim svoj rad da podelim sa publikom prvenstveno zato što ja kao vizuelni umetnik i jesam negde javno izložena i to tako i treba da bude. Na kraju krajeva ja moram samu sebe da promovišem.
Šta će biti u budućnosti?
Nastaviću da se razvijam kao umetnica, čini mi se da će naredne decenije biti usmerene na odnos tehnologije i umetnosti.
Mi smo neodvojivi od mikroorganizama, živimo zajedno i ne možemo jedni bez drugih, ta veza je neraskidiva. Ali kada se oni uzmu sa našeg tela i stave se na neko drugo mesto, mi postajemo svesniji šta posedujemo i da smo mi u stvari domaćini svim tim mikroorganizmima


